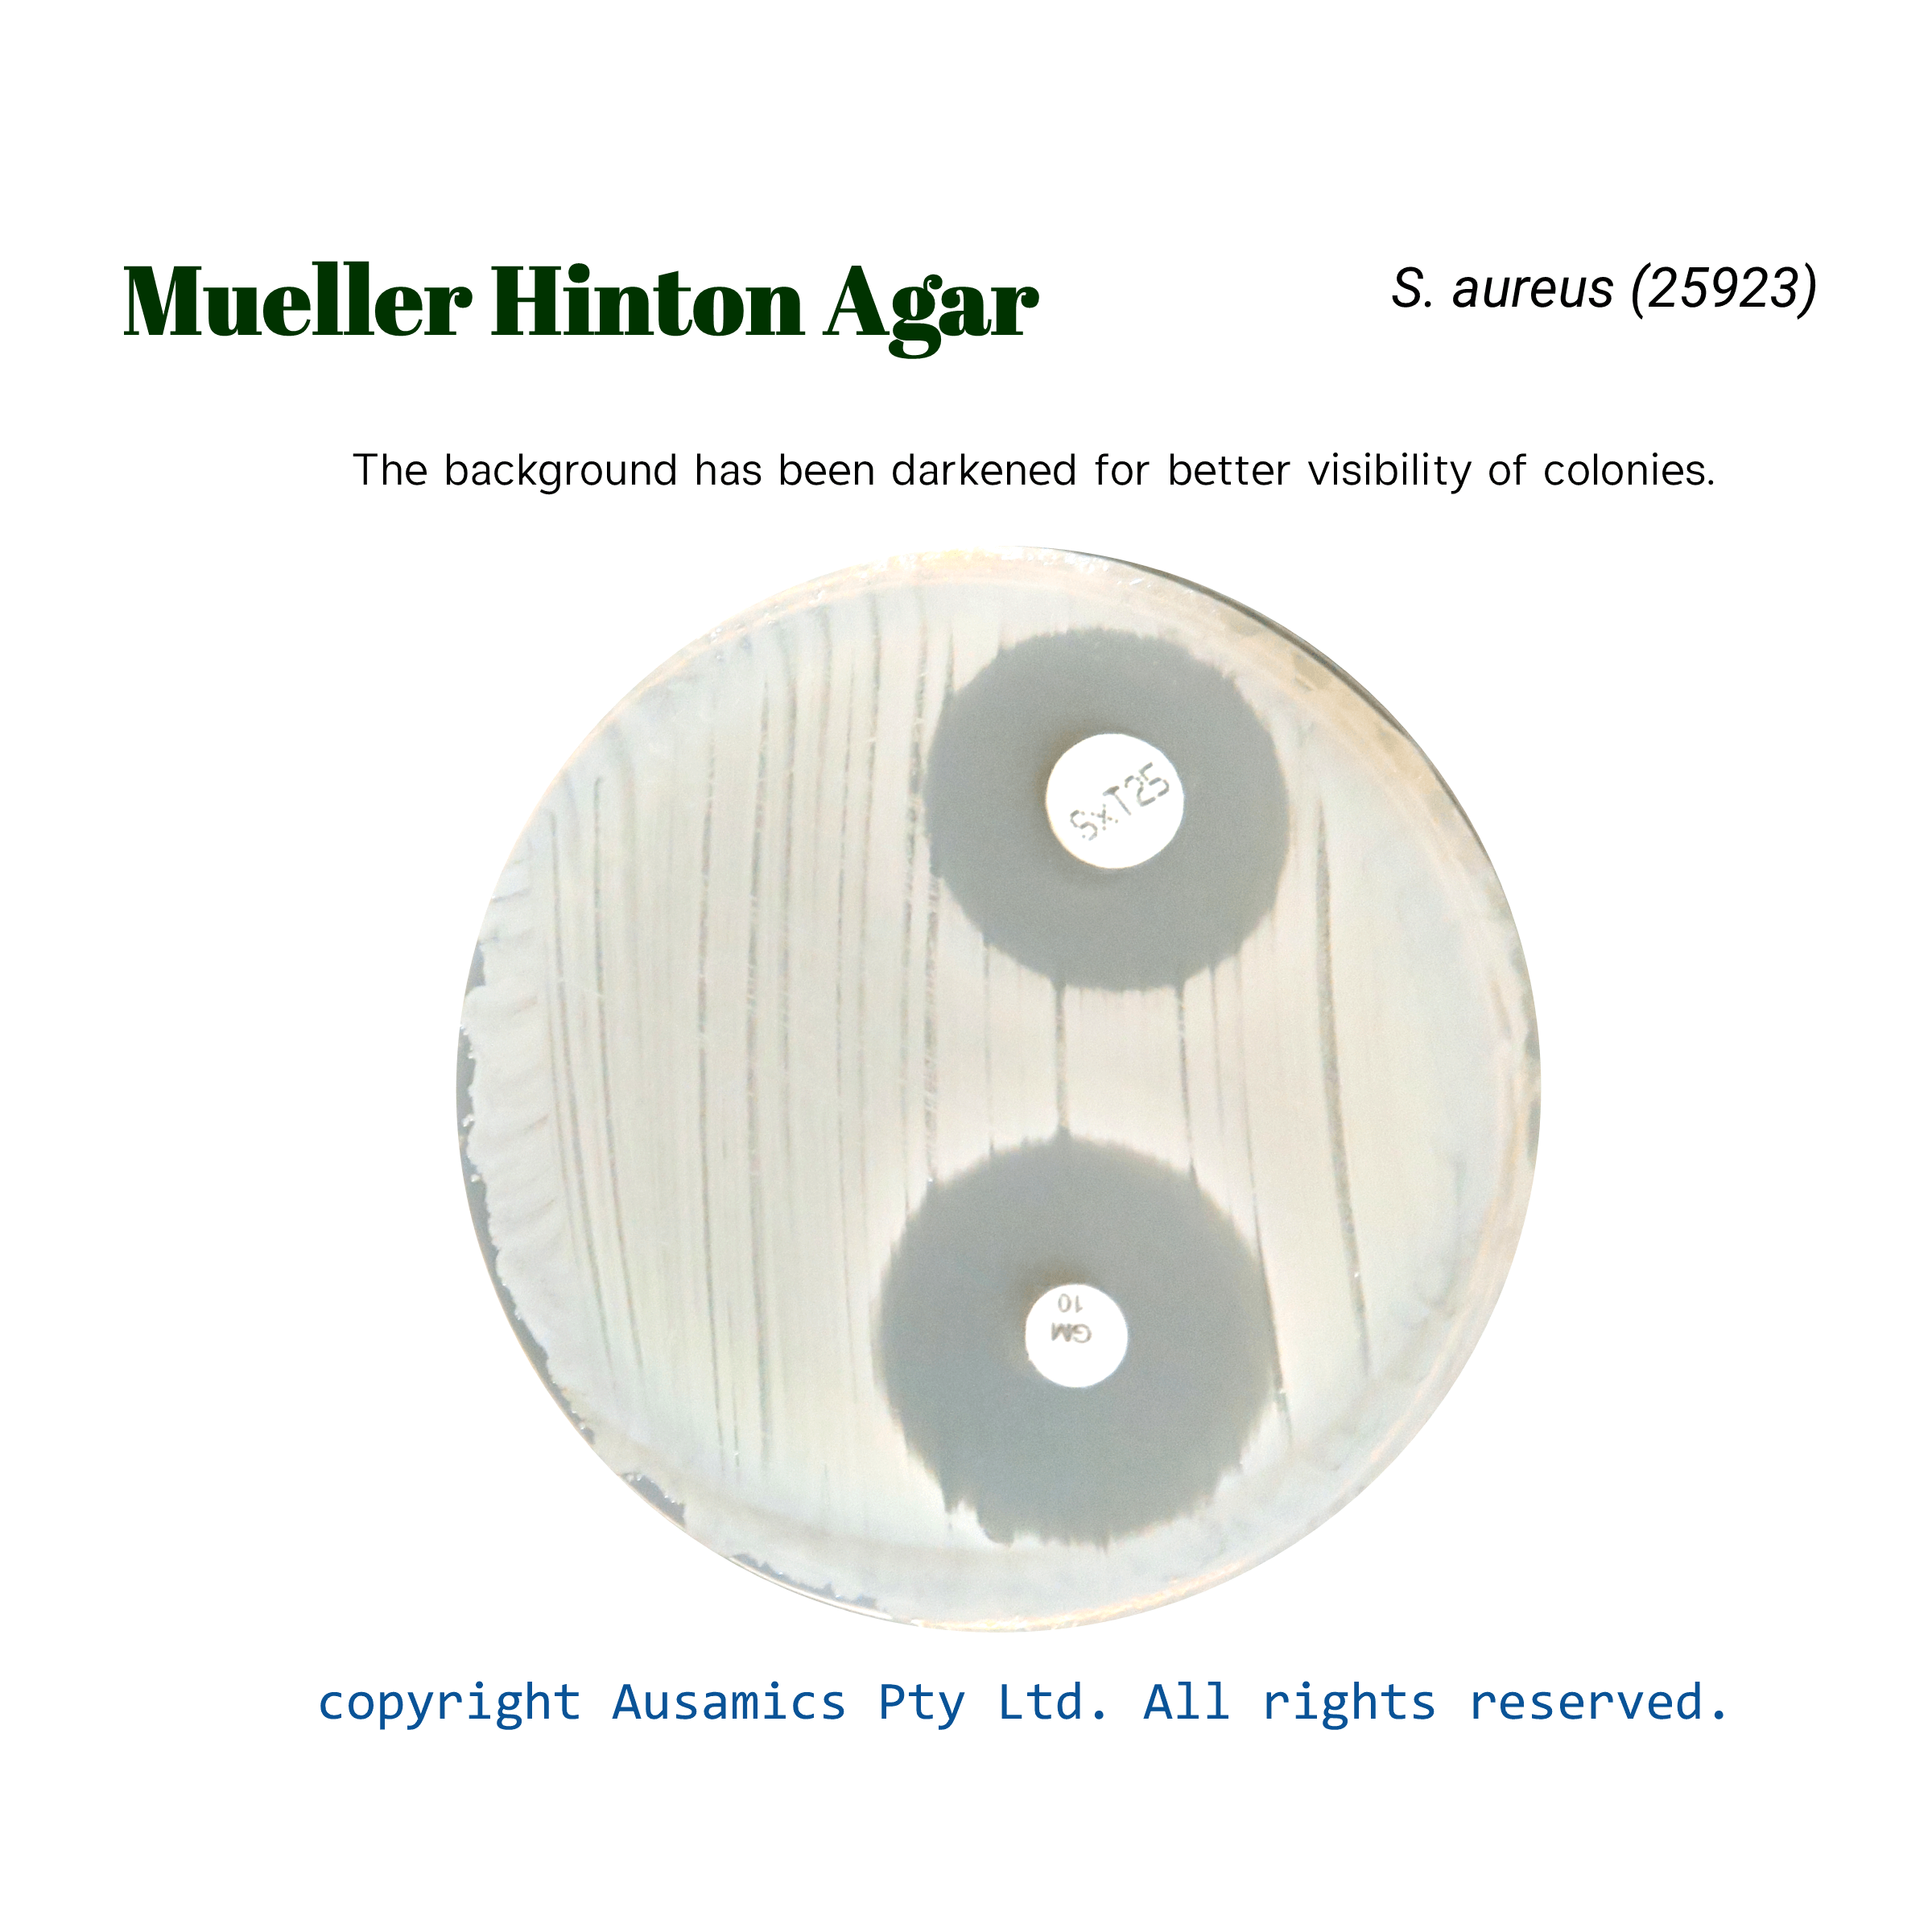

Mueller Hinton Agar
Is recommended for antimicrobial disc diffusion susceptibility testing of common, rapidly growing bacteria by the Bauer-Kirby method, as standardized by the CLSI.
- Description
- Composition
- Quality Control
- Microbial Test Results
Mueller Hinton Agar is a common culture medium that is frequently used for antimicrobial susceptibility testing (AST). It was created initially to cultivate pathogenic Neisseria species, but its versatility for a wide variety of non-fastidious bacteria makes it a good choice for industry standard for AST.
Peptones serve as the main source of nutrients, while starch provides a protective colloid. Its dependability in assessing bacterial sensitivity to antibiotics is attributed to its stable composition and minimal presence of compounds that inhibit antibiotic activity.
The standardized Kirby-Bauer disk diffusion method uses Mueller Hinton Agar and involves putting disks treated with antibiotics on the surface of the agar. The antibiotic’s effectiveness against the test organism is correlated with the diameter of the ensuing inhibition zones.
Mueller Hinton Agar has limitations while being useful for a wide range of bacteria, such as its inability for growth of fastidious organisms and the possible conflict between some antibiotic activity with blood supplements.
Storage
Keep the container at 15-30 °C and prepared medium at 2-8 °C.
| Composition | gr/L |
| Acid Hydrolysate of Casein | 17.5 |
| Beef Extract | 2 |
| Starch | 1.5 |
| Agar | 13 |
| Final pH at 25°C | 7.4 ± 0.2 |
| Dehydrated Appearance | Beige, free-flowing, homogeneous. |
| Prepared Appearance | Light to medium amber, slightly opalescent. |
| Reaction of 3.4% Solution at 25°C | pH 7.4 ± 0.2 |
| Inoculate plates with organisms listed below. Put antibiotic disks on the surface of the agar and incubate as recommended by CLSI. Measure zone diameters and compare to the CLSI recommended zone ranges. | |||
| Test disks | E. Coli (25922) | S. aureus (25923) | P. aeruginosa (27853) |
| Ampicillin 10 μg | 16-22 | 27-35 | – |
| Tetracycline 30 μg | 18-25 | 19-28 | – |
| Gentamicin 10 μg | 19-26 | 19-27 | 16-21 |
| Polymyxin B 300 IU | 12-17 | 7-13 | – |